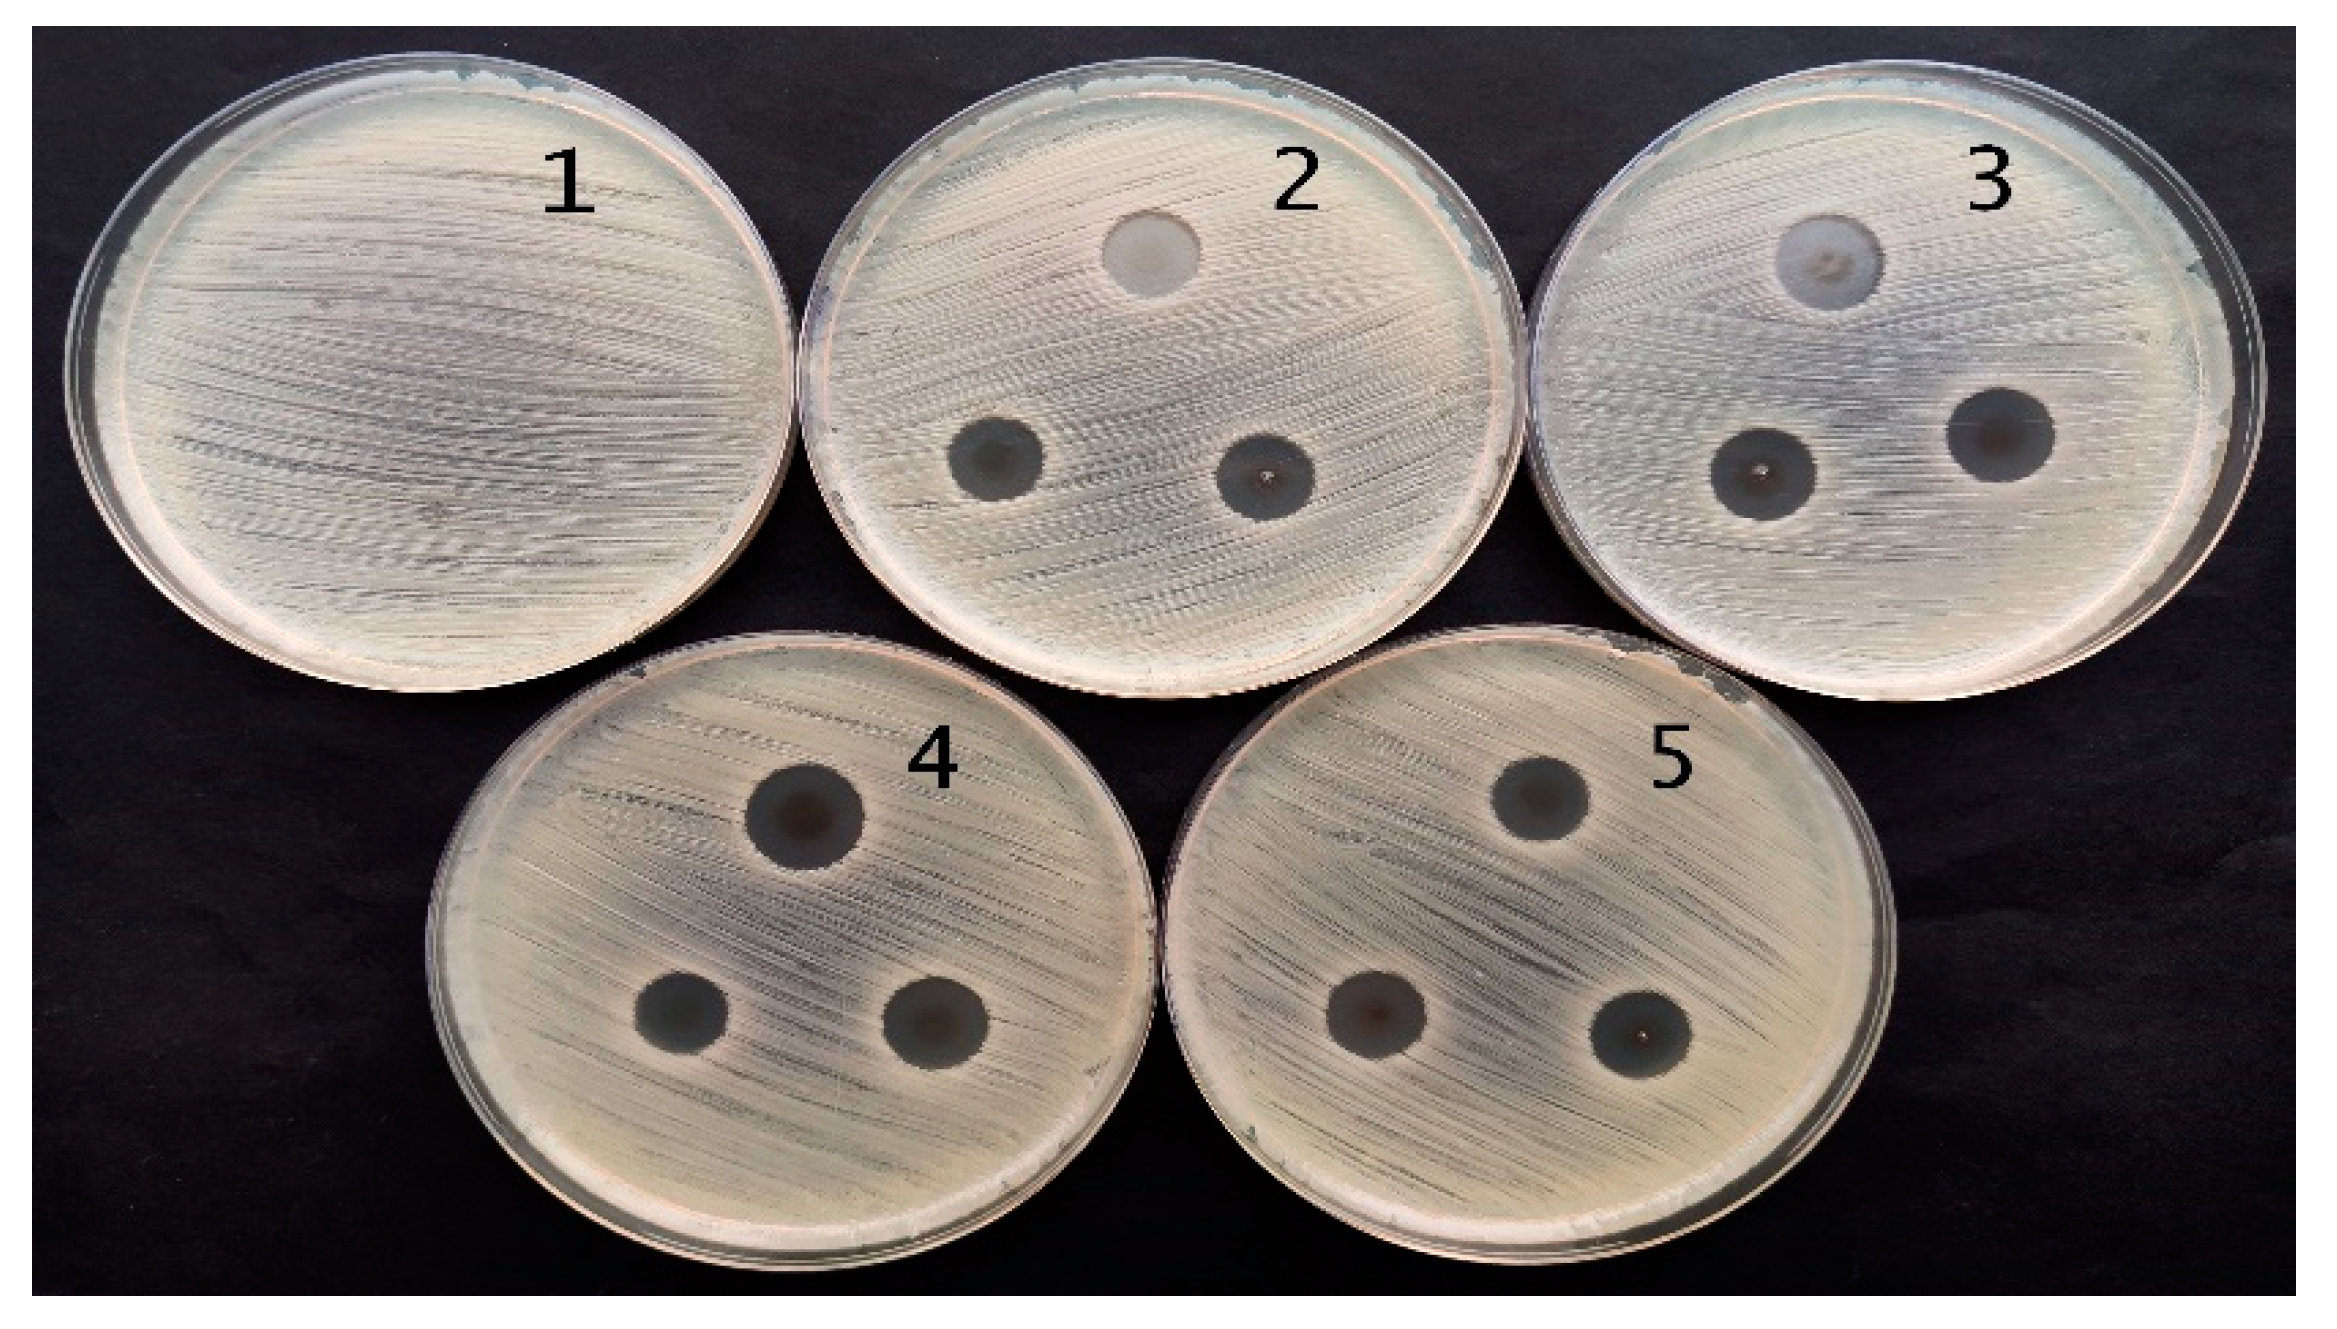
Gels 09 00498 g011
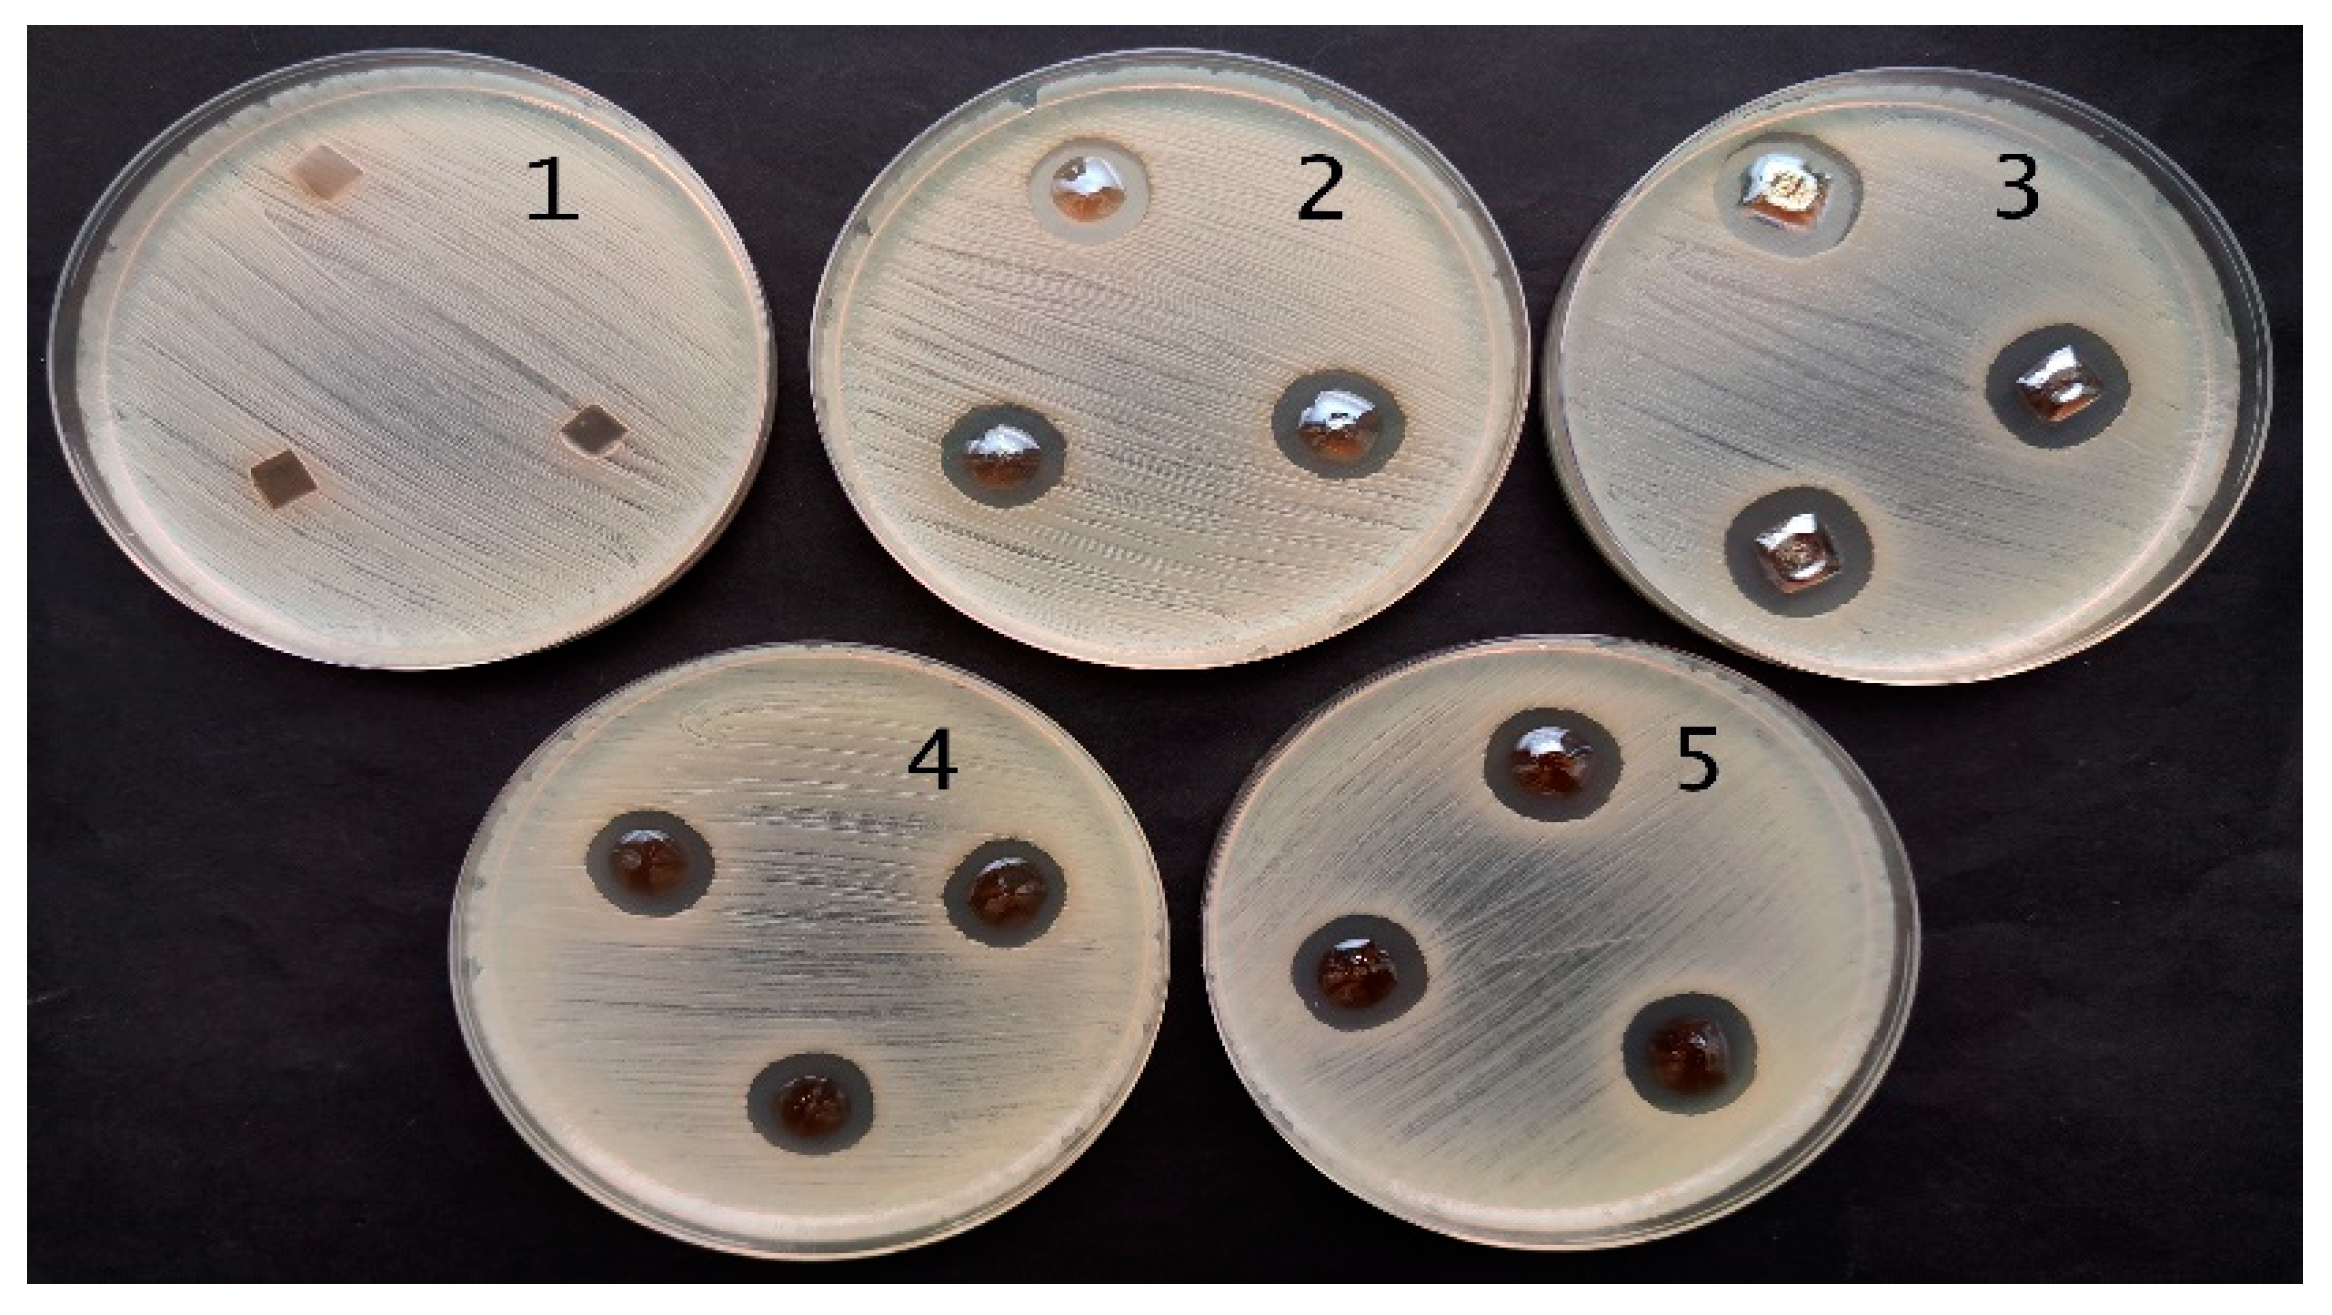
Gels 09 00498 g012

Application of Red Onion Peel Extract for Green Synthesis of Silver Nanoparticles in Hydrogels Exhibiting Antimicrobial Properties
Abstract
1. Introduction
2. Results and Discussion
2.1. Red Onion Peel Extract–Gelatin Gels with Silver Particles
2.2. Red Onion Peel–Gelatin Films Containing Silver Nanoparticles
2.2.1. UV-Vis Analysis
2.2.2. XRD Measurements
2.2.3. SEM and EDX Measurements
2.2.4. Swelling Behavior
2.3. Antimicrobial Activity of Red Onion Skin Extract Gels and Films with Silver Nanoparticles
3. Conclusions
4. Materials and Methods
4.1. Preparation of Silver Nitrate-Red Onion Extract-Gelatin Hydrogels
4.2. Formation of Silver Nitrate Red Onion Extract-Gelatin Films
4.3. UV Exposure of Experimental Samples
4.4. Instruments and Methods for Hydrogel Investigation
4.5. Microorganisms and Inoculum Preparation
4.6. Evaluation of the Antimicrobial Activity of the Red Onions Extracts Gels and Films Containing Silver Nanoparticles
Author Contributions
Funding
Institutional Review Board Statement
Informed Consent Statement
Data Availability Statement
Conflicts of Interest
References
- Griffiths, G.; Trueman, L.; Crowther, T.; Thomas, B.; Smith, B. Onions—A global benefit to health. Phytother. Res. 2002, 16, 603–615. [Google Scholar] [CrossRef] [PubMed]
- Slimestad, R.; Fossen, T.; Vågen, I.M. Onions: A Source of Unique Dietary Flavonoids. J. Agric. Food Chem. 2007, 55, 10067–10080. [Google Scholar] [CrossRef] [PubMed]
- Jaiswal, N.; Rizvi, S.I. Variation of Antioxidant Capacity in Different Layers of Onion (Allium cepa L.) at Two Different Stages of Maturation. Curr. Nutr. Food Sci. 2012, 8, 126–130. [Google Scholar] [CrossRef]
- El-Demerdash, F.M.; Yousef, M.I.; Abou, N.I.; I-Naga, E. Biochemical study on the hypoglycemic effects of onion and garlic in alloxan-induced diabetic rats. Food Chem. Toxicol. 2005, 43, 57–63. [Google Scholar] [CrossRef]
- Robards, K.; Antolovich, M. Analytical chemistry of frit bioflavonoids—A review. Analyst 1997, 122, 11R–34R. [Google Scholar] [CrossRef]
- Rodrigues, A.S.; Pérez-Gregorio, M.R.; García-Falcón, M.S.; Simal-Gándara, J. Effect of curing and cooking on flavonols and anthocyanins in traditional varieties of onion bulbs. Food Res. Int. 2009, 42, 1331–1336. [Google Scholar] [CrossRef]
- Rodrigues, A.S.; Almeida, D.P.; Simal-Gándara, J.; Pérez-Gregorio, M.R. Onions: A Source of Flavonoids. In Flavonoids—From Biosynthesis to Human Health; InTech: London, UK, 2017. [Google Scholar] [CrossRef]
- Dixon, R.A.; Paiva, N.L. Stress-induced phenylpropanoid metabolism. Plant Cell 1995, 7, 1085–1097. [Google Scholar] [CrossRef]
- Gennaro, L.; Leonardi, C.; Esposito, F.; Salucci, M.; Maiani, G.; Quaglia, G.; Fogliano, V. Flavonoid and Carbohydrate Contents in Tropea Red Onions: Effects of Homelike Peeling and Storage. J. Agric. Food Chem. 2002, 50, 1904–1910. [Google Scholar] [CrossRef]
- Fossen, T.; Andersen, Ø.M. Anthocyanins from red onion, Allium cepa, with novel aglycone. Phytochemistry 2003, 62, 1217–1220. [Google Scholar] [CrossRef]
- Okamoto, D.; Noguchi, Y.; Muro, T.; Morishita, M. Genetic Variation of Quercetin Glucoside Content in Onion (Allium cepa L.). J. Jpn. Soc. Hortic. Sci. 2006, 75, 100–108. [Google Scholar] [CrossRef]
- Sagar, N.A.; Pareek, S.; Benkeblia, N.; Xiao, J. Onion (Allium cepa L.) bioactives: Chemistry, pharmacotherapeutic functions, and industrial applications. Food Front. 2022, 3, 380–412. [Google Scholar] [CrossRef]
- Tedesco, I.; Carbone, V.; Spagnuolo, C.; Minasi, P.; Russo, G.L. Identification and Quantification of Flavonoids from Two Southern Italian Cultivars of Allium cepa L., Tropea (Red Onion) and Montoro (Copper Onion), and Their Capacity to Protect Human Erythrocytes from Oxidative Stress. J. Agric. Food Chem. 2015, 21, 5229–5238. [Google Scholar] [CrossRef] [PubMed]
- Nemeth, K.; Piskula, M.K. Food Content, Processing, Absorption and Metabolism of Onion Flavonoids. Crit. Rev. Food Sci. Nutr. 2007, 47, 397–409. [Google Scholar] [CrossRef]
- Ersoy, Ş.K.; Tütem, E.; Başkan, K.S.; Apak, R. Valorization of Red Onion Peels for Quercetin Recovery Using Quercetin-Imprinted Polymer. J. Chromatogr. Sci. 2020, 58, 163–170. [Google Scholar] [CrossRef] [PubMed]
- Modi, S.; Yadav, V.K.; Choudhary, N.; Alswieleh, A.M.; Sharma, A.K.; Bhardwaj, A.K.; Khan, S.H.; Yadav, K.K.; Cheon, J.-K.; Jeon, B.-H. Onion Peel Waste Mediated-Green Synthesis of Zinc Oxide Nanoparticles and Their Phytotoxicity on Mung Bean and Wheat Plant Growth. Materials 2022, 15, 2393. [Google Scholar] [CrossRef] [PubMed]
- Canbaz, G.T.; Açikel, Ü.; Açikel, Y.S. Green Synthesis of ZnO Nanoparticles from Onion Peel Wastes. In Proceedings of the 5th EurAsia Waste Management Symposium, Istanbul, Turkey, 26–28 October 2020. [Google Scholar]
- Abid, M.A.; Abid, D.A.; Aziz, W.J.; Rashid, T.M. Iron oxide nanoparticles synthesized using garlic and onion peel extracts rapidly degrade methylene blue dye. Phys. B Condens. Matter 2021, 622, 413277. [Google Scholar] [CrossRef]
- Aswathi, V.P.; Meera, S.; Maria, C.G.A.; Nidhin, M. Green synthesis of nanoparticles from biodegradable waste extracts and their applications: A critical review. Nanotechnol. Environ. Eng. 2022. [Google Scholar] [CrossRef]
- Lee, Y.J.; Kim, Y.K.; Park, Y. Folic Acid and Chitosan-Functionalized Gold Nanorods and Triangular Silver Nanoplates for the Delivery of Anticancer Agents. Int. J. Nanomed. 2022, 17, 1881–1902. [Google Scholar] [CrossRef]
- Phukan, K.; Devi, R.; Chowdhury, D. Insights into Anti-Inflammatory Activity and Internalization Pathway of Onion Peel-Derived Gold Nano Bioconjugates in RAW 264.7 Macrophages. ACS Omega 2022, 7, 7606–7615. [Google Scholar] [CrossRef]
- Khalilzadeh, M.A.; Borzoo, M. Green synthesis of silver nanoparticles using onion extract and their application for the preparation of a modified electrode for determination of ascorbic acid. J. Food Drug Anal. 2016, 24, 796–803. [Google Scholar] [CrossRef]
- Santhosh, A.; Theertha, V.; Prakash, P.; Chandran, S.S. From waste to a value added product: Green synthesis of silver nanoparticles from onion peels together with its diverse applications. Mater. Today: Proc. 2021, 46, 4460–4463. [Google Scholar] [CrossRef]
- Espina Palanco, M.; Bo Mogensen, K.; Gühlke, M.; Heiner, Z.; Kneipp, J.; Kneipp, K. Templated green synthesis of plasmonic silver nanoparticles in onion epidermal cells suitable for surface-enhanced Raman and hyper-Raman scattering. Beilstein J. Nanotechnol. 2016, 7, 834–840. [Google Scholar] [CrossRef] [PubMed]
- Vincent, J.; Lau, K.S.; Evyan, Y.C.-Y.; Chin, S.X.; Sillanpää, M.; Chia, C.H. Biogenic Synthesis of Copper-Based Nanomaterials Using Plant Extracts and Their Applications: Current and Future Directions. Nanomaterials 2022, 12, 3312. [Google Scholar] [CrossRef] [PubMed]
- Darroudi, M.; Ahmad, M.B.; Zak, A.K.; Zamiri, R.; Hakimi, M. Fabrication and Characterization of Gelatin Stabilized Silver Nanoparticles under UV-Light. Int. J. Mol. Sci. 2011, 12, 6346–6356. [Google Scholar] [CrossRef]
- Vanlalveni, C.; Lallianrawna, S.; Biswas, A.; Selvaraj, M.; Changmai, B.; Rokhum, S.L. Green synthesis of silver nanoparticles using plant extracts and their antimicrobial activities: A review of recent literature. RSC Adv. 2021, 11, 2804–2837. [Google Scholar] [CrossRef]
- Merken, H.M.; Beecher, G.R. Measurement of Food Flavonoids by High-Performance Liquid Chromatography: A Review. J. Agric. Food Chem. 2000, 48, 577–599. [Google Scholar] [CrossRef]
- Saha, S.; Singh, J.; Paul, A.; Sarkar, R.; Khan, Z.; Banerjee, K. Anthocyanin Profiling Using UV-Vis Spectroscopy and Liquid Chromatography Mass Spectrometry. J. AOAC Int. 2020, 103, 23–39. [Google Scholar] [CrossRef]
- Puišo, J.; Jonkuvienė, D.; Macioniene, I.; Šalomskienė, J.; Jasutienė, I.; Kondrotas, R. Biosynthesis of silver nanoparticles using lingonberry and cranberry juices and their antimicrobial activity. Colloids Surf. B Biointerfaces 2014, 121, 214–221. [Google Scholar] [CrossRef]
- Merkis, M.; Puišo, J.; Adliene, D.; Laurikaitiene, J. Development and Characterization of Silver Containing Free Standing Polymer FILMS for Dosimetry Applications. Polymers 2021, 13, 3925. [Google Scholar] [CrossRef]
- Puišo, J.; Adliene, D.; Paškevičius, A.; Vailionis, A. Investigation of the Antimicrobial Properties of Beetroot–Gelatin Films Containing Silver Particles Obtained via Green Synthesis. Appl. Sci. 2023, 13, 1926. [Google Scholar] [CrossRef]
- Giusti, M.; Wrolstad, R. Characterization and Measurement of Anthocyanins by UV-Visible Spectroscopy. Curr. Protoc. Food Anal. Chem. 2001, 1, F1.2.1–F1.2.13. [Google Scholar] [CrossRef]
- Fossen, T.; Slimestad, R.; Andersen, Ø.M. Anthocyanins with 4′-glucosidation from red onion, Allium cepa. Phytochemistry 2003, 64, 1367–1374. [Google Scholar] [CrossRef] [PubMed]
- Omidi, S.; Sedaghat, S.; Tahvildari, K.; Derakhshi, P.; Motiee, F. Biosynthesis of silver nanoparticles with adiantum capillus-veneris L leaf extract in the batch process and assessment of antibacterial activity. Green Chem. Lett. Rev. 2018, 11, 544–551. [Google Scholar] [CrossRef]
- Heath, J.R. Size-dependent surface-plasmon resonances of bare silver particles. Phys. Rev. B 1989, 40, 9982–9985. [Google Scholar] [CrossRef]
- Zhou, Y.Z.; Zhao, Y.; Wang, L.; Xu, L.; Zhai, M.; Wei, S. Radiation synthesis and characterization of nanosilver/gelatin/carboxymethyl chitosan hydroge. Radiat. Phys. Chem. 2012, 81, 553–560. [Google Scholar] [CrossRef]
- Otoni, C.G.; Avena-Bustillos, R.J.; Chiou, B.-S.; Bilbao-Sainz, C.; Bechtel, P.J.; McHugh, T.H. Ultraviolet-B Radiation Induced Cross-linking Improves Physical Properties of Cold- and Warm-Water Fish Gelatin Gels and Films. J. Food Sci. 2012, 77, E215–E223. [Google Scholar] [CrossRef]
- Meng, Y. A Sustainable Approach to Fabricating Ag Nanoparticles/PVA Hybrid Nanofiber and Its Catalytic Activity. Nanomaterials 2015, 5, 1124–1135. [Google Scholar] [CrossRef]
- Shruthi, G.; Prasad, K.S.; Vinod, T.P.; Balamurugan, V.; Shivamallu, C. Green Synthesis of Biologically Active Silver Nanoparticles through a Phyto-Mediated Approach Using Areca catechu Leaf Extract. Chemistryselect 2017, 2, 10354–10359. [Google Scholar] [CrossRef]
- Yiamsawas, D.; Kangwansupamonkon, W.; Chailapakul, O.; Kiatkamjornwong, S. Synthesis and swelling properties of poly[acrylamide-co-(crotonic acid)] superabsorbents. React. Funct. Polym. 2007, 67, 865–882. [Google Scholar] [CrossRef]
- Mohan, Y.M.; Premkumar, T.; Lee, K.; Geckeler, K.E. Fabrication of Silver Nanoparticles in Hydrogel Networks. Macromol. Rapid Commun. 2006, 27, 1346–1354. [Google Scholar] [CrossRef]
- Murthy, P.S.; Mohan, Y.M.; Varaprasad, K.; Sreedhar, B.; Mohana Raju, K.J. First successful design of semi-IPN hydrogel–silver nanocomposites: A facile approach for antibacterial application. Colloid Interface Sci. 2008, 318, 217–224. [Google Scholar] [CrossRef] [PubMed]
- Urnukhsaikhan, E.; Bold, B.-E.; Gunbileg, A.; Sukhbaatar, N.; Mishig-Ochir, T. Antibacterial activity and characteristics of silver nanoparticles biosynthesized from Carduus crispus. Sci. Rep. 2021, 11, 21047. [Google Scholar] [CrossRef]
- Sarwer, Q.; Amjad, M.S.; Mehmood, A.; Binish, Z.; Mustafa, G.; Farooq, A.; Qaseem, M.F.; Abasi, F.; de la Lastra, J.M.P. Green synthesis and characterization of silver nanoparticles using Myrsine africana leaf extract for their antibacterial, antioxidant and phytotoxic activities antimicrobial activity as compared with other hydrogels containing different plant extracts. Molecules 2022, 27, 7612. [Google Scholar] [CrossRef] [PubMed]
- Gomaa, E.Z. Antimicrobial, antioxidant and antitumor activities of silver nanoparticles synthesized by Allium cepa extract: A green approach. J. Genet. Eng. Biotechnol. 2017, 15, 49–57. [Google Scholar] [CrossRef] [PubMed]
- Lević, S.; Lijaković, I.P.; Đorđević, V.; Rac, V.; Rakić, V.; Knudsen, T.; Pavlović, V.; Bugarski, B.; Nedović, V. Characterization of sodium alginate/d-limonene emulsions and respective calcium alginate/d-limonene beads produced by electrostatic extrusion. Food Hydrocoll. 2015, 45, 111–123. [Google Scholar] [CrossRef]
- Wang, Y.; Xiong, Y.; Wang, J.; Zhang, X. Ultrasonic-assisted fabrication of montmorillonite-lignin hybrid hydrogel: Highly efficient swelling behaviors and super-sorbent for dye removal from wastewater. Colloids Surfaces A Physicochem. Eng. Asp. 2017, 520, 903–913. [Google Scholar] [CrossRef]

| Symbol | Series | UV = 0 min | UV = 5 min | UV = 10 min | UV = 20 min | UV = 60 min | |||||
|---|---|---|---|---|---|---|---|---|---|---|---|
| Atom. C [at. %] | Error [%] | Atom. C [at. %] | Error [%] | Atom. C [at. %] | Error [%] | Atom. C [at. %] | Error [%] | Atom. C [at. %] | Error [%] | ||
| C | Kα | 39.48 | 10.90 | 38.81 | 10.50 | 38.45 | 10.20 | 38.56 | 10.60 | 37.30 | 10.20 |
| O | Kα | 33.70 | 13.40 | 34.03 | 12.80 | 34.29 | 13.50 | 34.03 | 13.30 | 34.68 | 13.50 |
| N | Kα | 26.31 | 10.00 | 26.46 | 9.30 | 26.54 | 10.00 | 26.63 | 9.90 | 27.27 | 10.00 |
| S | Kα | 0.5 | 0.10 | 0.45 | 0.10 | 0.46 | 0.10 | 0.47 | 0.10 | 0.40 | 0.10 |
| Ag | Lα | - | - | 0.25 | 0.10 | 0.28 | 0.20 | 0.31 | 0.20 | 0.34 | 0.20 |
| Bacteria | Red Onion Peel-Gelatin | Red Onion Peel Extract | Exposure Duration Related Antimicrobial Activity of Hydrogels | Exposure Duration Related Antimicrobial Activity of Hydrogel Films | ||||||
|---|---|---|---|---|---|---|---|---|---|---|
| 5 min | 10 min | 20 min | 60 min | 5 min | 10 min | 20 min | 60 min | |||
| Size of the Inhibition Zone, mm | ||||||||||
| Staphylococcus aureus ATCC 29213 | 8.0 ± 0.0 | 0 | 11.3 ± 0.6 | 12.7 ± 0.6 | 11.0 ± 0.0 | 10.7 ± 0.6 | 14.0 ± 0.0 | 14.0 ± 0.6 | 15.3 ± 0.6 | 15.7 ± 0.6 |
| Acinetobacter baumannii BAA 747 | 6.0 ± 0.0 | 0 | 10.7 ± 0.6 | 11.0 ± 0.0 | 11.0 ± 0.0 | 11.0 ± 0.0 | 12.3 ± 0.6 | 13.0 ± 0.6 | 13.3 ± 0.6 | 12.0 ± 0.0 |
| Pseudomonas aeruginosa ATCC 15442 | 0 | 0 | 11.7 ± 0.6 | 13.0 ± 0.0 | 13.3 ± 0.6 | 12.3 ± 0.6 | 15.7 ± 0.6 | 18.7 ± 0.6 | 15.7 ± 0.6 | 17.3 ± 0.6 |
| Candida parapsilosis CBS 8836 | 0 | 0 | 6.0 ± 0.0 | 6.0 ± 0.0 | 6.0 ± 0.0 | 6.0 ± 0.0 | 6.0 ± 0.0 | 6.0 ± 0.0 | 6.0 ± 0.0 | 6.0 ± 0.0 |
| Candida albicans ATCC 90028 | 0 | 0 | 6.0 ± 0.0 | 6.0 ± 0.0 | 6.0 ± 0.0 | 6.0 ± 0.0 | 0 | 0 | 0 | 0 |
| Aspergillus flavus BTL G-33 | 0 | 0 | 0 | 0 | 0 | 0 | 6.0 ± 0.0 | 6.0 ± 0.0 | 6.0 ± 0.0 | 6.0 ± 0.0 |
| Aspergillus fumigatus BTL G-38 | 0 | 0 | 6.0 ± 0.0 | 6.0 ± 0.0 | 6.0 ± 0.0 | 6.0 ± 0.0 | 6.0 ± 0.0 | 6.0 ± 0.0 | 6.0 ± 0.0 | 6.0 ± 0.0 |
Disclaimer/Publisher’s Note: The statements, opinions and data contained in all publications are solely those of the individual author(s) and contributor(s) and not of MDPI and/or the editor(s). MDPI and/or the editor(s) disclaim responsibility for any injury to people or property resulting from any ideas, methods, instructions or products referred to in the content. |
© 2023 by the authors. Licensee MDPI, Basel, Switzerland. This article is an open access article distributed under the terms and conditions of the Creative Commons Attribution (CC BY) license (https://creativecommons.org/licenses/by/4.0/).
Share and Cite
Puišo, J.; Paškevičius, A.; Žvirgždas, J.; Dimitrova, T.L.; Litvakas, A.; Adliene, D. Application of Red Onion Peel Extract for Green Synthesis of Silver Nanoparticles in Hydrogels Exhibiting Antimicrobial Properties. Gels 2023, 9, 498. https://doi.org/10.3390/gels9060498
Puišo J, Paškevičius A, Žvirgždas J, Dimitrova TL, Litvakas A, Adliene D. Application of Red Onion Peel Extract for Green Synthesis of Silver Nanoparticles in Hydrogels Exhibiting Antimicrobial Properties. Gels. 2023; 9(6):498. https://doi.org/10.3390/gels9060498
Chicago/Turabian StylePuišo, Judita, Algimantas Paškevičius, Jonas Žvirgždas, Todorka L. Dimitrova, Andrejus Litvakas, and Diana Adliene. 2023. "Application of Red Onion Peel Extract for Green Synthesis of Silver Nanoparticles in Hydrogels Exhibiting Antimicrobial Properties" Gels 9, no. 6: 498. https://doi.org/10.3390/gels9060498
APA StylePuišo, J., Paškevičius, A., Žvirgždas, J., Dimitrova, T. L., Litvakas, A., & Adliene, D. (2023). Application of Red Onion Peel Extract for Green Synthesis of Silver Nanoparticles in Hydrogels Exhibiting Antimicrobial Properties. Gels, 9(6), 498. https://doi.org/10.3390/gels9060498

